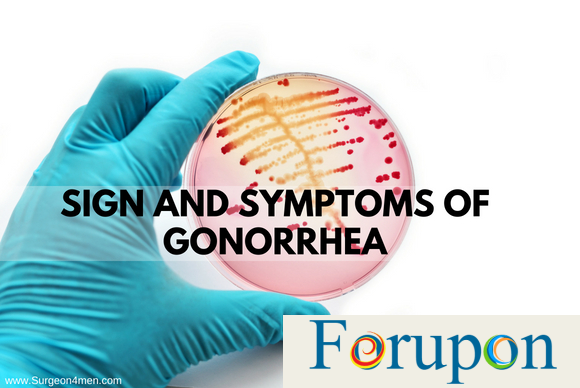

Gonorrhea vs Chlamydia: What’s the Difference?
For upon |In a 2015 report, the Centers for Disease Control and Prevention estimated that the United States sees 20 million new cases of STDs every year. STD rates have reached a record high. These STDs or STIs often can be transmitted through oral, anal, or vaginal sex and often do not show any symptoms.
The two most common STDs are chlamydia and gonorrhea. Each year almost 4 million people will contract one of these STDs. Both gonorrhea and chlamydia are bacterial infections that can serious health repercussions if left untreated, but are easily curable with doctor prescribed antibiotics. Read below to be better informed on the closely linked symptoms, side effects, and treatment.

What Causes Gonorrhea and Chlamydia?
Chlaymdia and Gonorrhea are sexually transmitted diseases (STDs) that affect both women and men. Both STDs are caused by a bacterial infection that affects the mucous membranes, which are moist, soft tissues not covered by our outer layer of skin. Chlamydia is caused by the bacteria, chlamydia trachomatis, and can be found in the vagina, cervix, urethra, and rectum as well as the throat or eyes (the lining in the eyelid). Gonorrhea, also called the “clap” or the “drip”, is caused by the bacteria, Neisseria gonorrhoeae. Like Chlamydia, gonorrhea bacteria can grow and infect women in the cervix, uterus, or fallopian tubes and in men, in the urethra. It can also infect the anus, mouth, and throat.
Chlamydia and gonorrhea are STDs, meaning they are transmitted by having oral, anal, or vaginal sex with a person who already has the disease. The infection is spread through semen and vaginal fluids, but the transmission of the disease is not dependent on ejaculation. While the infection comes from these fluids, it can infect the eyes and throat in addition to the vagina, cervix, penis, urethra, and anus. Anyone can get either disease, even if they have been diagnosed and treated for them before. However, since these fluids are required to transmit the bacteria, you cannot get either STD through casual contact. For example, it is not possible to get chlamydia or gonorrhea from holding hands, hugging, sneezing, sitting on a toilet, or sharing food. It is very unlikely to get chlamydia or gonorrhea from kissing, even kissing someone with the infection in their throat. Anyone can get either disease, even if they have been diagnosed and treated for them before.
Additionally, both STDs can pass onto newborns during childbirth if the mother is infected and remains untreated. The same risk factors, like having unprotected sex, having multiple sexual partners in a given time frame, and being between the ages of 14 and 24, apply to gonorrhea as well.
Certain traits do increase your likelihood of contracting both Chlamydia and gonorrhea:
- Engaging with multiple sexual partners in one year – The more partners who engage with, the more likely you will be exposed to an infected person and contract a STD.
- Having unprotected sex – Condoms can reduce the likelihood of you contracting a STD; however, condoms are never 100% effective. If you are concerned you may have a STD, you should get tested regardless of whether you used a condom in your last sexual encounter.
- Younger than 24 – Individuals younger than 24 tend to practice unprotected sex more often than other age groups and are less likely to be tested.
- Previous diagnosis of a STD – Having already contracted a STD increases your body’s susceptibility to contracting another STD. It can be common for those who have contracted chlamydia to be at risk for contracting gonorrhea or HIV. If you contract gonorrhea, you are at a greater risk of contracting HIV.
Can chalmydia turn into gonorrhea? No, Chlamydia on it’s own can not turn into gonorrhea as they are caused by two different bacteria. It does happen that people contract and carry both Chlamydia and gonorrhea bacteria, so you can have them at the same time. Also, having one increases your likelihood of contracting another; thus, it is always important to be treated for both.
Symptoms of Gonorrhea and Chlamydia
Sometimes someone with gonorrhea or chlamydia does not show any symptoms. In fact, 75% of women and 50% of men with chlamydia exhibit no symptoms. It is unclear how common it is with gonorrhea, but some estimates are that the majority of men and women show no symptoms. The key signs of gonorrhea and chalmydia can appear within one to three weeks after having sex with a partner with the STD. Even with no symptoms, it is still possible to transmit the disease and damage the reproductive system.
There are some differences in how both STD’s present in men vs women, but in general the most common reported symptoms in both men and women are:
- Discharge – For Chlamydia, women may have vaginal discharge that has a strong odor or is yellowish, and men may have cloudy or clear discharge around the tip of the penis. For Gonorrhea, women and men may have discharge from the vagina or penis that is green, yellow, or white.
- Burning sensation while urinating – Also called dysuria, this symptom is common with other STDs and is an important sign to get tested.
- Painful, burning sensations in infected area – For both STDs, this is most common inside the vagina for women and the penal opening for men. Additionally, throat infections from oral sex are common and can result in swollen glands in the throat.
Women can also have painful periods, bleeding between periods, pain during sex, abdominal pain, or a fever. Men can also have a less common symptom of swelling or pain in either or both testicles. Both can infect one or both eyes causing discharge, conjunctivitis (itchy, red eyes), or sensitivity to light. Both can also spread or infect the anus causing:
- Discharge
- Bleeding
- Rectal pain
Gonorrhea and Chlamydia can also exhibit very mild symptoms, leading some women to believe they have a yeast infection and self-treat with over the counter medication. Thus, it is important to consult a doctor to ensure you receive a proper diagnosis and treatment.
Complications from Chlamydia and Gonorrhea
Because these two diseases often have no symptoms, some people go untreated. Even with those who have symptom, stigma, access, or other reasons get in the way of getting medical attention. Not receiving prompt and proper treatment can create serious health problems.
For women, Chlamydia and gonorrhea that goes untreated can spread through your uterus to your fallopian tubes. Fallopian tubes connect the ovaries to the uterus and transport fertilized eggs during pregnancy. If untreated bacteria that cause gonorrhea and chlamydia spread to this area, the result is pelvic inflammatory disease (PID), affecting around 5% of women in the US.
Pelvic inflammatory disease, similar to Chlamydia and gonorrhea, can have no symptoms or just some pelvic or abdominal pain initially. Unfortunately, PID can do permanent damage to a women’s reproductive system, including:
- Long-term pelvic pain – PID can damage the fallopian tubes or other areas of the reproductive system inflaming them and causing chronic pelvic pain.
- Infertility – As the infection spreads through the fallopian tubes, the damage can cause scars that prevent any sperm from reaching an egg.
- Ectopic pregnancy – Sometimes, the sperm is able to get through and fertilize an egg, but the same damage and scarring can prevent the fertilized egg from reaching the uterus. This fertilized egg can implant in the fallopian tubes or elsewhere. Since these other areas are not designed to expand as the egg goes, they can rupture causing massive internal bleeding and even death. It is extremely important to call a doctor immediately, if you experience any symptoms, such as heavy vaginal bleeding, dizziness or shoulder pain.
- Premature birth – Even with the damage caused by the disease, it is still possible to conceive a child. Sometimes, PID can result in the birth occurring before the due-date, which can risk the health and development of the child.
For men, gonorrhea and chlamydia can also lead to serious health problems. It is uncommon for either to cause infertility in men, but sometimes the infection can spread past the penis causing fever or pain. One difference is that Chlamydia can also spread to the urethra, causing nongonoccoccal urethritis, which is an infection of the tube that carries urine resulting in inflammation, pain, and fever. This cannot be caused by the bacteria that causes gonorrhea. However, for both diseases, it is possible for either to cause:
- Epididymitis – This occurs when the epididymis is infected, the tube beside the testicle that carries sperm, which causes inflammation, scrotal pain, and fever.
- Proctitis – This results in inflammation of the rectum.
- Prostate gland infection – This is an infection of the prostate gland, which can cause fever, pain during sex or while urinating, and pain in the lower back.
For both women and men, Chlamydia and gonorrhea can develop into a form of arthritis. For Chlamydia, the disease is called reactive arthritis, or arthritis caused by the body’s reaction to an infection. This can affect the joints, urethra, and eyes. For gonorrhea, the bacteria can cause blood or joint infections resulting in a life threatening illness called disseminated gonococcal infection (DGI). Symptoms of DGI include joint pain, fever, and skin rashes or sores. Women are four times more likely to develop DGI than men. If you suspect you may have DGI, you should contact a doctor immediately as untreated DGI can permanently damage your joints.

Treatments for Gonorrhea and Chlamydia
Since both STDs are caused by a bacterial infection, the treatment is a regimen of oral antibiotics. Some strains of gonorrhea in the US have become antibiotic resistant, sometimes called “super gonorrhea”. Therefore, a medical physician will decide on the best course of antibiotics. The most commonly recommended antibiotics for both Chlamydia and gonorrhea are: ceftriaxone, cefixime, doxycycline, or azithromycin (the brand name is Zithromax). The infection should clear after one to two weeks. You should never stop taking antibiotics until the recommended course is finished, even if you think the infection cleared or you are feeling better. If you do not finish the antibiotics, the infection can come back and be resistant to the antibiotics you were taking. Additionally, since antibiotic resistant strains of bacteria are already more common, if your symptoms continue after a few days of taking antibiotics, consult your doctor. They may switch you to a different strain of antibiotics. Some people report home remedies for Chlamydia and gonorrhea easing their symptoms, but the only effective treatment for both STDs are antibiotics.
Gonorrhea and Chlamydia are curable by taking the appropriate medication as directed; however, repeat infections are common. You and your sexual partner(s) should always be tested after three months of completing treatment, especially if you are unsure whether your partner(s) received treatment.
Your and your sexual partner(s) should not have sex again until treatment is complete. You should wait at least one week after completing a prescribed single dose medication. You should finish all doses if you are prescribed a seven-day treatment. In some cases, the infection may still be present, so you should wait until you and your partner(s) are sure the disease is no longer present.
When to Contact a Doctor
If you have any of the symptoms described, you should go see a doctor. In general, if you are sexually active and have any usual discharge, burning sensations, or pain while having sex; you may have a STD and should get tested.
Additionally, if you are a woman, you should contact a doctor immediately if you have any of the following symptoms as they can be a sign of a serious complication of chlamydia called pelvic inflammatory disease:
- Vomiting
- Fainting or signs of shock
- Serious lower abdominal pain
- Temperature that is higher than 101 F
Should any of these symptoms arise or if you suspect you may have a STD, it is very important to get tested. Even if you have no symptoms as do the vast majority of those with chlamydia but are sexually active, you should be getting tested regularly, so you do not unknowingly spread the disease. You can make an appointment with your primary care physician or see an urgent care in order to be tested and receive treatment.
The article was originally published here.

Comments are closed.